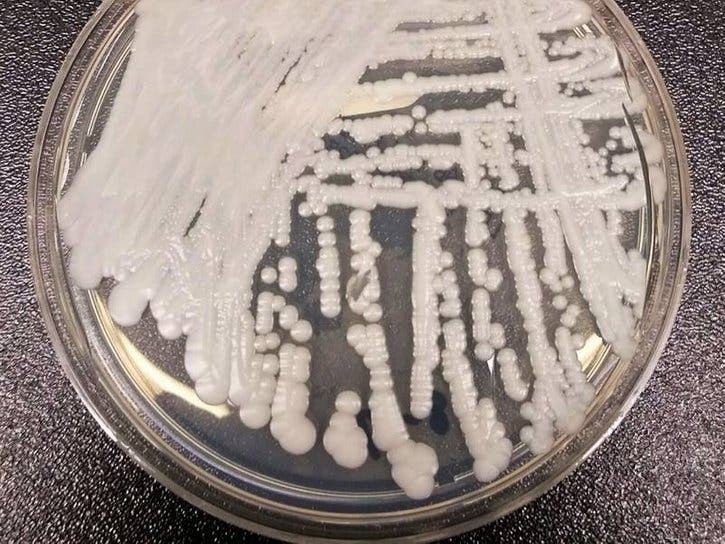
A strain of Candida auris cultured in a petri dish at a Centers for Disease Control and Prevention laboratory.

Health & Fitness
Deadly Superbug Candida Auris Reaches California
At least two people in California have caught Candida auris, a drug-resistant fungus first detected in Japan in 2009.
CALIFORNIA — A deadly, drug-resistant infection first discovered in the U.S. in 2013 has reached California. Candida auris is a fungus that targets people with weak immune systems. About half of those who contract the infection die, according to the Centers for Disease Control and Prevention.
Two people have been diagnosed with C. auris in California, according to the CDC. There have been 587 cases across the country, including 309 in New York.
The infection was first discovered in Japan in 2009.
Find out what's happening in Lamorindafor free with the latest updates from Patch.
"Candida auris is an emerging fungus that presents a serious global health threat," the CDC says. "Patients can remain ... with C. auris for a long time and C. auris can persist on surfaces in healthcare environments. This can result in spread of C. auris between patients in healthcare facilities."
The CDC said it's concerned about the infection because it's difficult to identify, resistant to multiple drugs and can easily spread in hospitals.
Find out what's happening in Lamorindafor free with the latest updates from Patch.
C. auris is a form of yeast, though its origin is unknown.
"It is a creature from the black lagoon," Dr. Tom Chiller, of the CDC, told The New York Times. "It bubbled up and now it is everywhere."
The infection has been detected in Canada, England, Russia, Australia and Colombia.
Candida auris cases in the U.S. since 2013

Candida auris fact sheet by Jason Claffey on Scribd
— Patch editors Jason Claffey and Bea Karnes contributed to this story
Also See:
- San Francisco Hospital Among Best In World, New Analysis Says
- 10 Calif. Restaurants Earn AAA 5-Diamond Rating 2019
- List Of All ‘Diners, Drive-Ins and Dives’ Restaurants In Northern California
- Sunset Over Wildflower Rimmed Creek: Photo Of The Day
- High School Senior Wins $40K College Scholarship
- 2019 California Distinguished Schools: Full List
Get more local news delivered straight to your inbox. Sign up for free Patch newsletters and alerts.